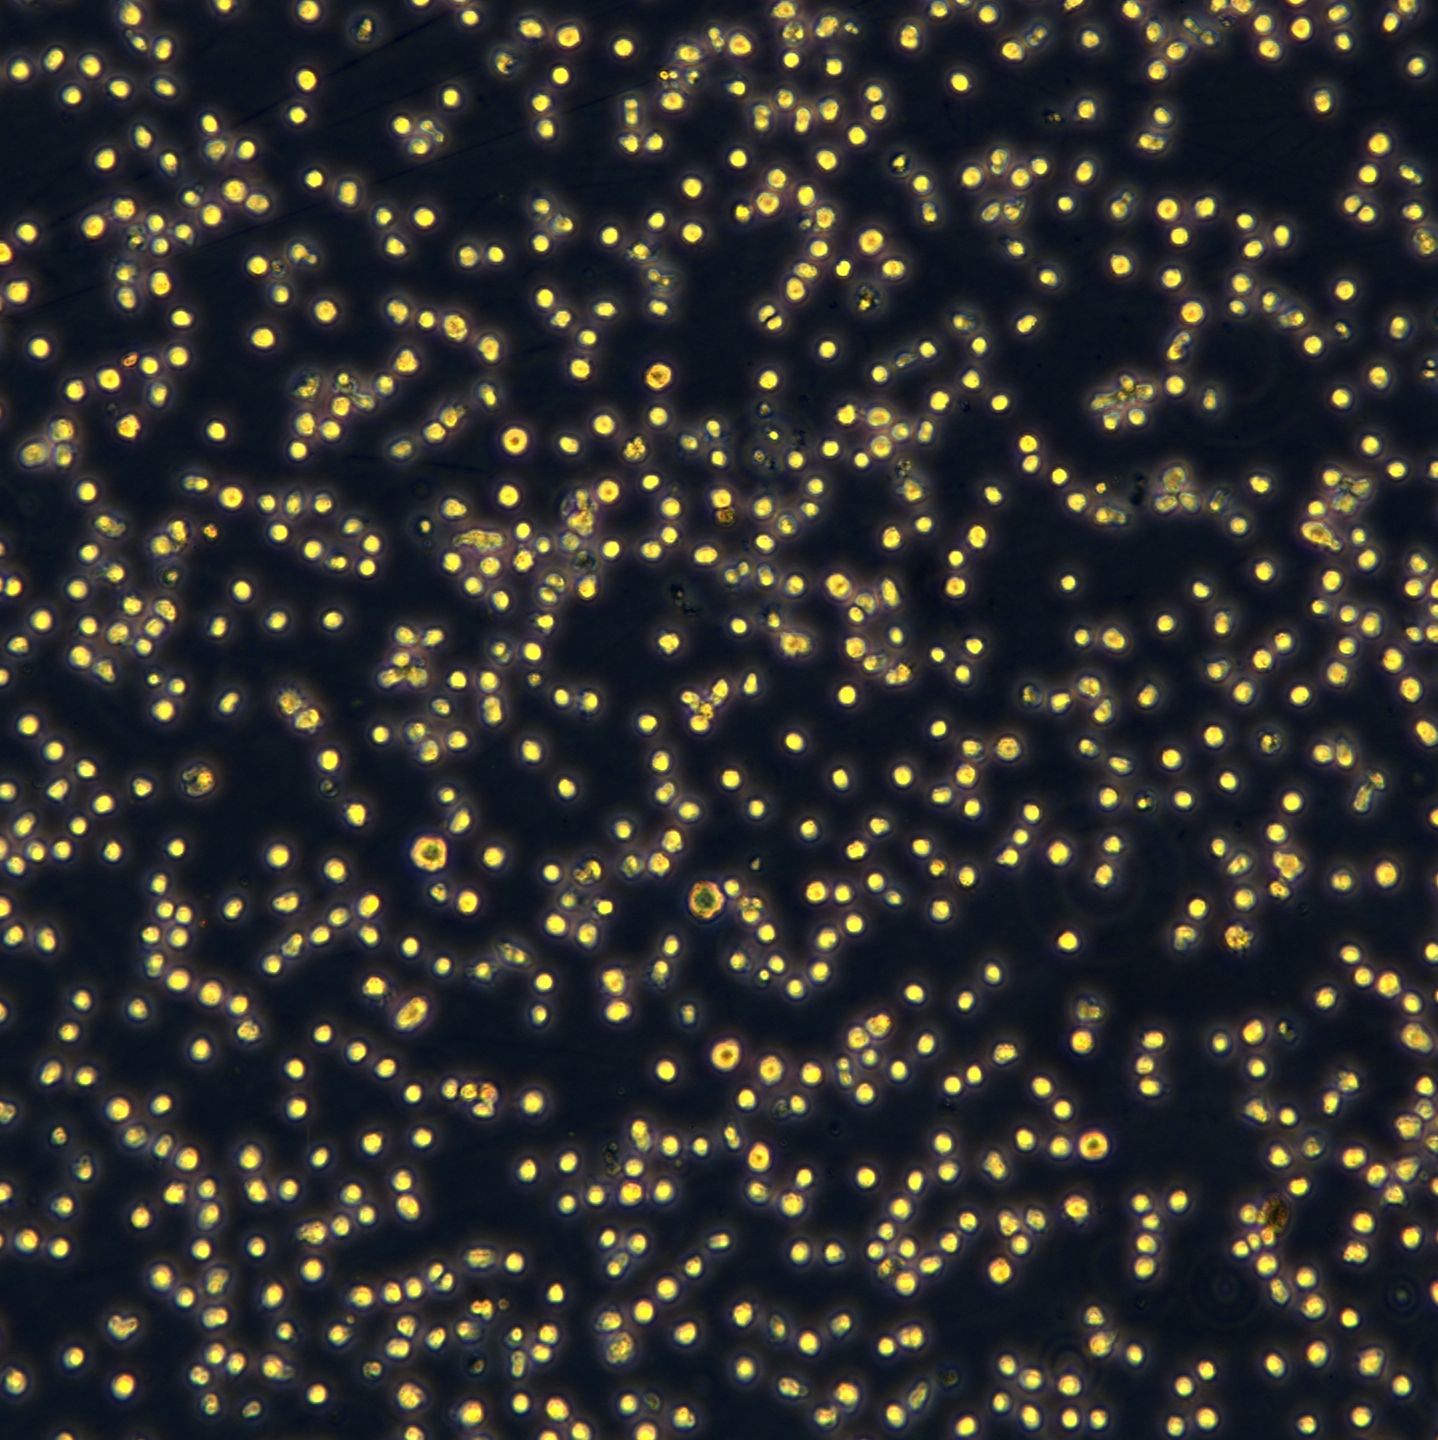
产品封面图

相关产品推荐更多 >
万千商家帮你免费找货
0 人在求购买到急需产品
- 详细信息
- 文献和实验
- 技术资料
- 英文名:
Karpas422
- 库存:
99
- 组织来源:
胸腔积液(Pleural effusion)
- 相关疾病:
淋巴瘤(Lymphoma)
- 物种来源:
人源(Homo sapiens)
- 细胞形态:
B细胞淋巴瘤(B cell lymphoma)
- 运输方式:
常温或干冰冻存发货 空运、快递
- 年限:
73岁(73 years)
- 生长状态:
悬浮生长(Suspension)


| 规格 | T25 |
| 货号 | CTCC-007-0202 |
| 种属 | 人源(Homo sapiens) |
| 组织来源 | 胸腔积液(Pleural effusion) |
| 疾病 | 淋巴瘤(Lymphoma) |
| 年龄 | 73岁(73 years) |
| 培养体系 | 该细胞系培养所用基本培养基为 RPMI1640 Medium,配置完全培养基时 需加入20%FBS,1% Anti-Anti。 |
| 细胞形态 | B细胞淋巴瘤(B cell lymphoma) |
| 生长特性 | 悬浮生长(Suspension) |
风险提示:丁香通仅作为第三方平台,为商家信息发布提供平台空间。用户咨询产品时请注意保护个人信息及财产安全,合理判断,谨慎选购商品,商家和用户对交易行为负责。对于医疗器械类产品,请先查证核实企业经营资质和医疗器械产品注册证情况。
文献和实验Protein Expression and Purification of RPA70-AB (181-422)
Comments: pSV281 RPA70AB Constructed by L.Mizoue; May '02.This plasmid encodes RPA 70 subunit residues 181-422 as a fusion protein with an NT 6His tag.The tag can be cleaved off with TEV protease (recognition site is ENLFYQG)leaving "GS" at NT
三句话读懂一篇 CNS!首次提取超 100 万年的 DNA;轻轻一喷,瞬时改变作物性状...
with reprogrammed specificity。该研究搭建了一种新型蛋白定向进化平台,并借助该平台定向进化一种天然的蛋白酶(源自细菌肉毒素的轻链),进一步地改变其特异性,使之切割磷酸酯酶与张力蛋白同源物(PTEN)等其它细胞内源性蛋白。 该工作首次建立了一套蛋白酶定向进化方法,具有重大科学应用价值,后续开发出更灵活通用的工具令人期待!图片来源:Science 5. NEJM: 随访数据公布,非霍奇金淋巴瘤治疗取得好成绩 弥散性大 B 细胞淋巴瘤(DLBCL)约占全球非霍奇金淋巴瘤(NHL)病例的 30%,是最常
整合 CAR-T 疗法就是最强武器。该治疗复发难治性非霍奇金淋巴瘤的临床试验结果表明:87.5%(7/8)的患者获得疾病完全缓解,5 例无癌生存已超过 1 年,首例接受治疗的患者已无癌生存 2 年! 1.文章介绍 论著题目:Non-viral, specifically targeted CAR-T cells achieve high safety and efficacy in B-NHL 发表期刊:Nature 影响因子:69.504(2022 年最新数据) 2.实验基础信息 单细胞